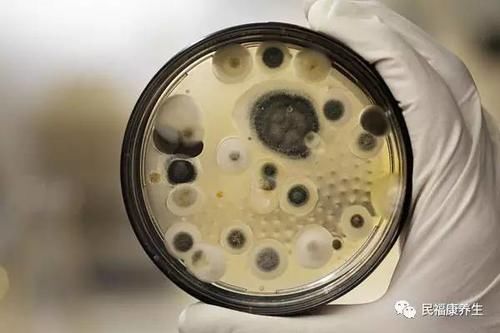
霉菌性阴炎怎么根治 霉菌性阴炎这样吃药好

老公要同时服用治疗霉菌的药物,或者涂药,才能完全杜绝。医生告诉我很多时候患病是因为老公有带菌,同房即有可能再次被感染。霉菌在男人身体完全不反应,因此容易被忽视

怎样彻底治好霉菌性中耳炎
480x300 - 18KB - JPEG

霉菌性阴道炎能彻底根治吗?
600x337 - 16KB - JPEG

为了根治霉菌性湿疹,我彻底拼命了!--产业速递
500x323 - 253KB - PNG

霉菌性阴炎怎么根治
472x305 - 12KB - JPEG

如何根治霉菌性阴道炎
420x420 - 58KB - JPEG

为了根治霉菌性湿疹,我彻底拼命了!--产业速递
492x379 - 547KB - PNG

顽固的妇科疾病 霉菌性阴炎怎么根治
500x375 - 19KB - JPEG

如何快速治愈霉菌性阴道炎
450x503 - 40KB - JPEG

霉菌性阴炎怎么根治 霉菌性阴炎这样吃药好
500x333 - 13KB - JPEG

如何快速治愈霉菌性阴道炎
538x450 - 152KB - JPEG

霉菌性阴道炎该如何根治?
553x553 - 114KB - PNG

霉菌性阴道炎老复发?药没用对
500x332 - 122KB - JPEG

霉菌性阴炎怎么根治 霉菌性阴炎这样吃药好
500x333 - 22KB - JPEG
霉菌性阴炎怎么根治 霉菌性阴炎这样吃药好
500x333 - 22KB - JPEG

脚气怎样才能彻底治好?有哪些注意事项?
400x299 - 18KB - JPEG